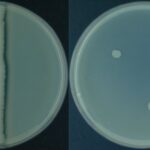
Casein Hydrolysis Test Principle, Procedure, Result

Biology Notes Online
Complete Biology Toolkit in One Place
Biology Notes Online is your all in one platform to study smart and score high with free notes, mcq, mock test course, flashcards, videos, quizzes and doubt support in one place
Question Submission Rules:
- Questions must be clear and specific
- Include all relevant details and context
- No spam or inappropriate content
- One question per submission
- Maximum image size: 5MB
- Supported image formats: JPG, PNG, GIF
Features
Study Notes, Lecture Videos, Mock test, Flashcards, MCQ, Audio Overview, Course, Exam Notes, Doubt Solve
Explore Notes Topic Wise
Explore Microbiology Notes Topics Wise
Explore Zoology Notes Topics Wise
Explore Botany Notes Topics Wise
Exam Notes
Study Notes Built on Your Exam Syllabus – No Fluff, Just What the Exam Wants
Free Lecture Videos
Detailed Free Lecture Videos Covering Every Bio Topic – Watch & Master Easily
Free Biology Courses
From B.Sc to M.Sc topics, Semester Syllabus? We’ve Got You Covered, Start to Finish!
All Biology Topics
Explore Every Branch of Biology – Dive Deep, Scroll Wide, Learn Fast
- Agricultural Microbiology 12 posts
- Bacteriology 104 posts
- Basic Microbiology 94 posts
- Biochemistry 106 posts
- Bioinformatics 25 posts
- Biotechnology 13 posts
- Cell Biology 134 posts
- Disease 7 posts
- Ecology 33 posts
- Environmental Microbiology 69 posts
- Epidemiology 1 post
- Food Microbiology 58 posts
- Genetics 100 posts
- Immunology 108 posts
- Industrial microbiology 24 posts
- Intellectual Property Rights 9 posts
- Medical Microbiology 37 posts
- Microbiologists 8 posts
- Microscope 28 posts
- Molecular biology 87 posts
- Mycology 49 posts
- Parasitology 34 posts
- Phycology 25 posts
- Prions 2 posts
- Protozoa 16 posts
- Virology 67 posts
- Angiosperms 32 posts
- Archegoniate 12 posts
- Biodiversity 1 post
- Economic Botany 15 posts
- Ethnobotany 5 posts
- Horticultural 10 posts
- Natural Resource Management 3 posts
- Plant Anatomy and Embryology 19 posts
- Plant Breeding 16 posts
- Plant Ecology and Taxonomy 15 posts
- Plant Physiology and Metabolism 19 posts
- Animal Behaviour 1 post
- Basic Zoology 6 posts
- Biology of Insecta 15 posts
- Chordates 27 posts
- Developmental Biology 22 posts
- Endocrinology 17 posts
- Ethology 6 posts
- Evolutionary Biology 21 posts
- Fish and fisheries 25 posts
- Human Anatomy 15 posts
- Neuroscience 17 posts
- Non-chordates 20 posts
- Pest Management 5 posts
- Physiology 52 posts
- Protista 15 posts
- Reproductive Biology 5 posts
- Research Methodology 8 posts
- Vertebrata 13 posts
- Biochemical Test 97 posts
- Botany Practicals 2 posts
- Culture Media 79 posts
- Cytopathology 1 post
- Hematology 7 posts
- Immunology Practical 19 posts
- Instruments 153 posts
- Laboratory Techniques 5 posts
- Laboratory Tests 16 posts
- Microbiology Techniques 25 posts
- Protocols 18 posts
- Solution preparation 21 posts
- Staining 43 posts
- Under Microscope 26 posts
- Differences 184 notes
- Intellectual Property Rights 9 notes
- Question Papers 6 notes
- Recommended Books 59 notes
- Research Methodology 8 notes
- Syllabus 12 notes
- Top in Biology 13 notes
- Universities and Colleges 1 post
- Worksheet 20 notes
- Bacteriology 104 posts
- Mycology 49 posts
- Parasitology 34 posts
- Phycology 25 posts
- Prions 2 posts
- Protozoa 16 posts
- Virology 67 posts
Latest Notes
Free Doubt Solve
Got Questions? We’ve Got Bio Answers – Clear, Quick, and to the Point
Voices of Our Users
This was very useful
Discover the Microscopic World
Share and explore stunning microscopic images of microorganisms in our growing community.